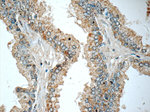
HSD17B6 Antibody in Immunohistochemistry (Paraffin) (IHC (P))
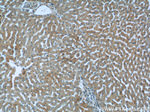
HSD17B6 Antibody in Immunohistochemistry (Paraffin) (IHC (P))

Search
Proteintech
HSD17B6 Polyclonal Antibody
{{$productOrderCtrl.translations['antibody.pdp.commerceCard.promotion.promotions']}}
{{$productOrderCtrl.translations['antibody.pdp.commerceCard.promotion.viewpromo']}}
{{$productOrderCtrl.translations['antibody.pdp.commerceCard.promotion.promocode']}}: {{promo.promoCode}} {{promo.promoTitle}} {{promo.promoDescription}}. {{$productOrderCtrl.translations['antibody.pdp.commerceCard.promotion.learnmore']}}
产品信息
11855-1-AP
种属反应
已发表种属
宿主/亚型
分类
类型
抗原
偶联物
形式
浓度
规格
纯化类型
保存液
内含物
保存条件
运输条件
产品详细信息
Immunogen sequence: MWLYLAAFV GLYYLLHWYR ERQVVSHLQD KYVFITGCDS GFGNLLARQL DARGLRVLAA CLTEKGAEQL RGQTSDRLET VTLDVTKMES IAAATQWVKE HVGDRGLWGL VNNAGILTPI TLCEWLNTED SMNMLKVNLI GVIQVTLSML PLVRRARGRI VNVSSILGRV AFFVGGYCVS KYGVEAFSDI LRREIQHFGV KISIVEPGYF RTGMTNMTQS LERMKQSWKE APKHIKETYG QQYFDALYNI MKEGLLNCST NLNLVTDCME HALTSVHPRT RYSAGWDAKF FFIPLSYLPT SLADYILTRS WPKPAQAV (1-317 aa encoded by BC020710)
靶标信息
The protein encoded by this gene has both oxidoreductase and epimerase activities and is involved in androgen catabolism. The oxidoreductase activity can convert 3 alpha-adiol to dihydrotestosterone, while the epimerase activity can convert androsterone to epi-androsterone. Both reactions use NAD+ as the preferred cofactor. This gene is a member of the retinol dehydrogenase family. Transcript variants utilizing alternative polyadenylation signals exist.
仅用于科研。不用于诊断过程。未经明确授权不得转售。
生物信息学
蛋白别名: 17-beta-HSD 6; 17-beta-HSD6; 17-beta-HSD9; 17-beta-hydroxysteroid dehydrogenase type 6; 3(alpha->beta)-hydroxysteroid epimerase; 3(alpha->beta)-hydroxysteroid epimerasel; 3-alpha->beta-HSE; 3-alpha->beta-hydroxysteroid epimerase; 3-hydroxysteroid epimerase; hydroxysteroid (17-beta) dehydrogenase 6 homolog; hydroxysteroid (17-beta) dehydrogenase 9; hydroxysteroid 17-beta dehydrogenase 9; NAD+ -dependent 3 alpha-hydroxysteroid dehydrogenase 3-hydroxysteroid epimerase; oxidative 17 beta hydroxysteroid dehydrogenase type 6; Oxidative 3-alpha hydroxysteroid dehydrogenase; oxidative 3-alpha-hydroxysteroid-dehydrogenase; oxidoreductase; retinol dehydrogenase; Short chain dehydrogenase/reductase family 9C member 6; unnamed protein product
基因别名: 17betaHSD9; Gm182; HSD17B6; Hsd17b9; HSE; Rdh8; RODH; SDR9C6
UniProt ID: (Human) O14756, (Rat) O54753, (Mouse) Q9R092
Entrez Gene ID: (Human) 8630, (Rat) 286964, (Mouse) 27400